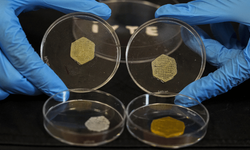
İzmir'de geliştirilen "yara örtüsü" kronik yaralar için umut olacak

Baykar Genel Müdürü Haluk Bayraktar, yaptığı paylaşımda Baltık bölgesindeki önemli faaliyetlerinden biri olan Steadfast Dart 2026 Tatbikatı kapsamında TCG ANADOLU'dan havalanan Bayraktar TB3'ün Eurofighter'larla ortak görevinde 8 saat uçup 1700 kilometre mesafe katettiğini belirtti.
Bayraktar TB3’ün gerçekleştirdiği uzun süreli uçuş, platformun dayanıklılık, haberleşme ve müşterek görev kabiliyetlerini ortaya koydu.
Baltık Bölgesi gibi yoğun hava trafiği ve NATO hava unsurlarının entegre şekilde faaliyet yürüttüğü ortamda TB3’ün Eurofighter'larla koordineli görev icrası, Türkiye’nin insansız sistemlerinin NATO standardizasyonuna uyum seviyesini gösteren önemli bir unsur oldu.
Bu durum aynı zamanda Türk savunma sanayisinin insansız sistemler alanında ulaştığı olgunluk seviyesinin, ittifak görevlerine entegre edilebilir aşamaya geldiğini gösterdi.
Eurofighter uçaklarıyla görev icrası, insanlı ve insansız platformların birlikte görev yapması beklenen geleceğin muharebe konsepti açısından da test niteliği taşıyor.
Türkiye’nin tedarik sürecini yürüttüğü Eurofighter Typhoon savaş uçaklarının Türk Hava Kuvvetleri envanterine katılmasıyla, TB3 gibi platformlarla birlikte çalışabilirlik kritik hale gelecek.
✈️ #BayraktarTB3 ⚓️🚀
— BAYKAR (@BaykarTech) February 20, 2026
⚓️ TCG ANADOLU
🛫 Steadfast Dart-2026 NATO Tatbikatı | Exercise
🤝 Eurofighter'larla Ortak Tatbikat
🕐 Baltık Denizi | 8 Saat Uçuş
📍 1.700 km Mesafe
🤝 Joint Exercise with Eurofighters
🕐 Baltic Sea | 8 Hours of Flight
📍 1,700 km Distance… pic.twitter.com/UDWLRDbC03